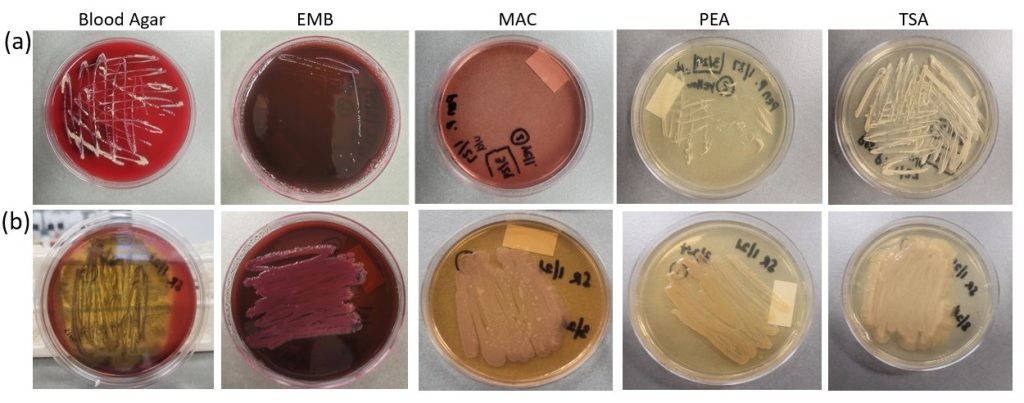

Abstract
Water quality analysis of Philadelphia County surface waters have indicated that storm events alter the concentrations of pollutants such as polycyclic aromatic hydrocarbons (PAHs), antibiotics, heavy metals, and other pollutants, which could impact aquatic organisms’ diversity as well as human health. However, there is limited knowledge regarding the microbial communities in these environments and their responses to these pollutants. To address this knowledge gap, culturing and analysis of genomes isolated from surface water samples was carried out at two different time points: one under average conditions (SW1) and another three days after a storm event (SW2). Colorimetric water quality assays were also employed to assess the levels of common pollutants in waterways and observe alterations in the relative concentrations of various chemicals in the Schuylkill River after storm events. Gram staining, and culture analysis of isolated colonies from surface waters in Philadelphia County waterways was performed to understand microbial diversity and the principles of bacterial identification. Genomic DNA was extracted from bacteria concentrated via filtration. PCR amplification of the 16s rRNA gene was performed in preparation for genomic sequencing. Genomic sequencing of samples from various waterways was performed and analyzed using bioinformatics software to identify microorganisms and classify taxa. The results demonstrate that storm events influence the diversity of microorganisms in the Delaware River Watershed. Further analysis of pollutant levels and the metagenomic data will be needed to further elucidate the correlation between specific pollutants and potential pathogens as well as the influence of said pollutants on microbial diversity.
Keywords: water quality, pollution, genomics, metataxonomics, metagenomics, microbial ecology, microbial diversity, conservation
© 2023 under the terms of the J ATE Open Access Publishing Agreement
Introduction
Microorganisms play a fundamental role in maintaining the stability of freshwater ecosystems [1]. Aquatic biofilms and surface waters serve as the foundation for numerous ecosystems, playing a crucial role in stabilizing and maintaining the balance of these systems [2]. Biofilms have the remarkable ability to develop in various interfacial environments and establish themselves on a wide range of organic and inorganic substrates [3, 4]. Biofilm colonization contributes to the stabilization of sediments against re-suspension [5]. The majority of microorganisms in freshwater ecosystems are found in biofilms which increase hydrodynamic transient storage—stream water detained in quiescent zones, removing organic nutrients and influencing biogeochemical processes downstream [6]. The bacterial populations present in freshwater ecosystems have a significant impact on organic matter generation and breakdown, the decomposition of numerous environmental contaminants, and the intricate cycling of elements such as nitrogen, sulfur, and various metals [7].
The biodiversity of natural biofilms and their surface waters are directly linked to the metabolic performance of these communities, influencing the overall functioning of aquatic systems [5]. However, the health and integrity of biofilms and surface water microbial ecosystems can be significantly affected by various factors, including anthropogenic pollution [8-10]. Recently, a study of Singapore rivers indicated the wide occurrence of trace levels of 14 common antibiotics [10]. Climate change and droughts, nutrient enrichment, and alterations stemming from human activities like the release of contaminants from wastewater and stormwater, extraction of natural resources, and runoff from agricultural areas are the primary contributors to the formation of detrimental algal blooms [9]. It is evident that the movement of disease-causing microorganisms across land through surface runoff is a significant factor contributing to the rise in levels of waterborne pathogens within streams in numerous watersheds [11]. Contaminants in rivers, including drug residues, metals, and different types of waste, contribute to the dissemination of antibiotic resistance genes (ARGs) facilitated by mobile genetic elements (MGEs) [12].
The influx of runoff into surface water systems, as evidenced by heightened turbidity caused by soil particles eroded from the surroundings, is linked to higher levels of bacteria, Giardia, Cryptosporidium, and other microscopic organisms [13]. The pathogens typically associated with waterborne diseases encompass enteric viruses sourced from human fecal contamination, bacterial pathogens typified by Escherichia coli O157:H7, and protozoan pathogens such as Cryptosporidium and Giardia [11]. Pollutants such as polycyclic aromatic hydrocarbons (PAHs) in waterways pose a threat to both freshwater and marine ecosystems [14]. Additionally, the release of hydrocarbons and chemical dispersants into marine environments can disrupt benthic ecosystems, including natural and artificial reefs, as well as the organisms associated with them [15]. Urban environments also contribute to the pollution of aquatic ecosystems, particularly through untreated stormwater. Recent studies in Paris indicated that out of the 88 substances studied, the stormwater was found to be polluted by 55 different chemical compounds [16]. Stormwater runoff, amplified by climate change, poses a significant challenge for cities like Philadelphia, which lies at the bottom of a vast drainage system. Interestingly, urban sampling sites the Code River in Indonesia exhibited reduced bacterial diversity and higher levels of antibiotic resistance genes (ARGs), which showed a correlation with mobile genetic elements (MGEs). This indicates an enhanced potential for gene mobility in response to the impacts of human activities [17]. In Philadelphia, increased turbidity has been associated with increased gastrointestinal illness of both children and the elderly [18, 19]. As a result of climate change, the Philadelphia stormwater management system needs to handle increasingly intense storms, which necessitates costly modernization efforts [20].
From a worldwide perspective, the greatest health threat to humans arises from the presence of disease-causing agents in drinking water. Throughout history, numerous instances of disease outbreaks and poisonings have occurred due to people being exposed to untreated or inadequately treated drinking water [21]. In Europe and North America during the Industrial Revolution, a network of pipes was constructed to divert water from streets, initially to prevent flooding. Later, these pipes were extended to connect houses and businesses, allowing direct disposal of sanitary sewage waste into nearby waterways [21]. Combined sewer systems later connected these pipes to wastewater treatment plants. Over half of the global population resides in urban areas, making urban waters crucial spaces where human activities intersect with the natural environment [22]. Older American cities still possess such combined sewers, which frequently overflow during heavy rainfall, leading to the discharge of untreated sewage mixed with stormwater into nearby rivers [23]. Recent research conducted in Milwaukee suggests that the predominant origin of fecal contamination seems to stem from sewage-related sources rather than non-human sources based on the ratios of human Bacteroides to total Bacteroides spp. from samples at four out of five river locations receiving stormwater discharge [24]. Roughly 60% of Philadelphia’s population is serviced by a combined sewer system, which facilitates the transportation of both stormwater runoff and wastewater from residential and commercial structures [25]. In temperate ecosystems, pulsed nutrients from storm events frequently drive macroalgal blooms [26, 27]. Following the cessation of rainfall, it may require a span of up to 48 hours for the water in the vicinity of the Combined Sewer Overflow (CSO) to recover [28]. Sampling SW at 72 hours may be more appropriate for observing the impact on the microbial community present before the discharge event, rather than being masked by the presence of microorganisms present in the CSO discharge event. Urban waters serve as collection basins for various landscape activities and runoff from storm drains, and studying their microbiome can offer valuable information about the effects of pollution, the presence of potential health risks for humans, and the potential long-term consequences for both ecosystems and the communities relying on them.
To assess the impact of pollutants on surface water and the associated microbiomes in surface waters, we adopted a comprehensive biochemical, molecular biological, and metataxonomic approach. By analyzing surface water samples obtained from surface waters at two different time points (one during average conditions and another three days after a storm event), this study aims to investigate the response of aquatic microbiomes to anthropogenic pollution and storm run-off. The utilization of metataxonomics focuses solely on the analysis of the 16S rRNA gene to classify and even identify bacteria to determine the diversity of microorganisms in samples [29]. Work on the earth microbiome project used metataxonomics to confirm the major compositional distinction between saline and non-saline microbial communities throughout the world [30].
Through this research, it is expected that stormwater runoff and raw sewage discharge will lead to alterations in microbial diversity within Philadelphia’s waterways. The assessment will encompass direct cell counts, genomics analysis to evaluate species richness, and comparisons between tributaries of The Delaware Watershed. Furthermore, changes in microbial gene expression are anticipated in populations cultured from surface water samples and biofilms after exposure to contaminants. It is also expected that post-storm surface water samples may exhibit virulence factors associated with pathogens.
This study’s outcomes will contribute to a better understanding of the impact of stormwater runoff and raw sewage discharge on microbial communities in surface waters. Furthermore, the findings will support the development of controlled laboratory microcosms to further investigate the effects of storm water runoff and raw sewage discharge on microbial communities in surface waters.
Methods
Water Sampling
Surface water samples from various Delaware watershed waterways were collected using sterile Samples were collected for the presence of microorganisms according to protocols used by the PA DEP [31]. Although it is common to sample 1L, when conducting PCR based analyses 150mL are commonly used by the PA DEP and who they reference Wade et. al (2010) [31]. Briefly, 150mL Nalgene plastic bottles were autoclaved prior to sampling. In the field, sterile nitrile gloves were donned prior to sampling flowing surface waters at the sampling sites. Samples were collected by Grab Sampling, by dipping the container in the water and filling it to 150mL. Subsequent to sampling, containers were placed on ice at 4°C prior to transport to the laboratory. Samples were stored at 4°C for 3-5 days prior to filtration and genomic DNA extraction, due to time constraints of the participants. Although this can result in sample degradation, it has been shown that little significant degradation of water samples stored in such a manner occurs between 2-5 days post sampling when stored at 4°C [32]. Pre-storm samples were taken 0n 10/1/2022 where the average temperature was 17°C and skies were cloudy. On 10/02/2022, Philadelphia County and surrounding counties received a reported 2-inch precipitation event, one commonly known to overwhelm combined sewer overflow systems. The post-storm samples were taken on 10/05/2022 where the average temperature was 15°C. The rain proceeded from 10/1-10/5 2022, though at lower levels.
Water Quality Analysis
Prior to the concentration of microorganisms on Filters, SW samples from various sources were tested using the SJ Wave 16 in 1 Drinking Water Test Kit (SJWave.com). The test strips test for Total Hardness: 0-425PPM, Free Chlorine: 0-10PPM, Iron: 0-500PPM, Copper: 0-10PPM, Lead: 0-500PPM, Nitrate: 0-500PPM, Nitrite: 0-80PPM, MPS: 0-20PPM, Total Chlorine: 0-10PPM, Fluoride: 0-100PPM, Cyanuric Acid: 0-250PPM, Ammonia Chloride: 0-500PPM, Bromine: 0-20PPM, Total Alkalinity: 0-240PPM, Carbonate: 0-240PPM, pH: 6-9. Briefly, Test strips were immersed in 5ml of SW sample and the colorimetric changes observed were recorded within 5 minutes. Samples were obtained in triplicate and averaged.
Concentration of Microorganisms on Filters
Filter towers fitted with 0.2µm filter towers (Corning, NY) were used to capture bacteria and other microorganisms from water samples. Surface water samples from the desired locations were collected using sterile containers. Filtration apparatuses were prepared by assembling the filter unit onto the vacuum filtration system and connecting it to the vacuum source. Water samples of volume 150 mL were poured into the filter towers while ensuring that no air bubbles were trapped. After applying vacuum pressure to initiate filtration, water passed through the filter membrane, retaining bacteria and other microorganisms on the filter surface. Filters were carefully removed from the filter tower and placed in a sterile petri dish using sterile forceps. Sterile scalpels were used to mince filters into 1 cm by 0.25 cm strips. Filters were stored in microcentrifuge tubes at -20°C prior to genomic DNA extraction.
Isolation of Genomic DNA from SW Samples
Mixed genomic DNA of microorganisms was isolated from SW samples concentrated onto 0.02 µm filters using The PureLink™ Microbiome DNA Purification Kit (Catalog Number A29790, Thermo Fisher, Waltham, MA). This kit enabled the purification of high-quality microbial DNA from filter paper or environmental swab samples. It utilizes spin-column technology for robust DNA yields that are suitable for downstream PCR, sequencing, or other applications. The typical DNA recovery from SW or environmental swab samples is 0.1–1 µg. The procedure involved lysing microorganisms using a combination of heat, chemical, and mechanical disruption with specialized beads. Inhibitors were eliminated through precipitation using a proprietary cleanup method. The purified DNA was then bound to a spin column, underwent a single wash step, and was eluted for use or storage.
PCR Amplification of the 16s rDNA gene from mixed genomic DNA samples
The 16s rDNA gene from genomic DNA isolated from Philadelphia Waterways was amplified using Applied Biosystems™ MicroSEQ™ Full Gene 16S rDNA PCR Kit (Thermo Fisher, Waltham, MA) (Catalog number: 4349155). Three PCR reactions were prepared for each sample or control, with one PCR Master Mix for each. The master mix included Taq Polymerase, dNTPs, and primers flanking the beginning, middle, and end of the 16s rDNA gene (530, 742, and 724 bp respectively) at 0.2 uM final concentration. The negative control consisted of 15 μL of PCR Master Mix 1, 2, or 3 along with 15 μL of ultrapure PCR grade water supplied with the kit. Samples included 15 μL of PCR Master Mix 1, 2, or 3 and a 15 μL sample of genomic DNA extracted from Philadelphia Waterways. Positive controls contained 15 μL of PCR Master Mix 1, 2, or 3 and 15 μL of positive-control E. coli DNA. PCR cycling involved setting the thermal cycling conditions, starting with an initial step at 95°C for 10 min, followed by 30 cycles of melting at 95°C for 30 seconds, annealing at 60°C for 30 seconds, and extending at 72°C for 45 seconds, concluding with a final extension step at 72°C for 10 min.
Gel electrophoresis of PCR Products
Agarose gels of either 0.5% concentration (for genomic DNA) and 2% (for PCR products), were poured according to standard protocols, and 10 μL of PCR product per lane was loaded into the gel. The gel was placed into a submarine gel electrophoresis chamber containing 1x TBE solution. The samples were electrophoresed at 100 V for 40 min prior to visualization on a BIORAD Chemidoc V3 Western Workflow system (Catalogue # 4561029, Hercules, CA).
DNA Sequencing
Genomic DNA templates (~20 ng/μL per sample) were sent to the GenWiz Agenta facility at (South Plainfield, NJ) for 16S rRNA gene amplification and sequencing. Samples were pooled into a library, quantified, and run on an Illumina MiSeq platform (Illumina Inc., San Diego, CA, USA), generating 300 bp, paired-end sequences.
Bioinformatics Analysis
Bioinformatics analysis of raw partial 16S rDNA sequences was carried out using QIIME2 pipeline generated through the online resource Nephele [33]. Merged sequences (2.2 M) were quality filtered, discarding reads with a maximum number of expected errors >0.5 (based on Phred quality scores) [34]. A total of 1.08M sequences, with an average sequence length of 434 base pairs, were obtained after quality filtering. Sequences were de-replicated, and remaining sequences assigned to OTUs based on greedy clustering and ≥97% sequence similarity. A table containing the relative abundance of OTUs in each sample was generated. A representative sequence from each OTU was used for taxonomic identification and alignment using UCLUST and the GreenGenes reference database (v 13.8) [35].
Results and Discussion
In order to analyze the microbial diversity of surface waters in response to pollutant exposure and storm run-off, a comprehensive approach was taken. This employed diverse methodologies, including filtering water samples, gram staining isolates from water samples, culturing microorganisms on selective and differential media, genomic DNA extraction, PCR amplification of the 16S rRNA gene, DNA sequencing, and determination of species diversity using bioinformatics/metataxonomics.

Collection of Surface Waters Pre and Post Storm from Tributaries of The Delaware Watershed (Fig. 1.).
The figure depicts a map illustrating the locations in the Philadelphia region where water samples were collected. The map displays the geographical area of Philadelphia County. Various points or markers (red) are plotted on the map, indicating the specific locations where water samples were taken. Water samples were taken from the same geographic location pre and post storm events. Samples were collected in sterile 150mL bottles prior to processing in the laboratory and were kept at 4°C for no more than 3 days.

Gram Stain of Representative Microorganisms from Philadelphia County Surface Waters (Fig. 2.). TSA (Tryptic Soy Agar) plates were inoculated with 100 mL of SW from various samples. Representative colonies were picked from each TSA plate, were fixed to glass slides, and stained using the gram stain protocol [36]. Images were taken at 400x using a Leica fluorescent microscope using brightfield settings. Fig. 2a shows an example of a gram positive bacteria from the Wissahickon Creek. Fig. 2b shows an example of a gram negative bacteria from the Wissahickon Creek.
Microorganisms Isolated from Various Surface Waters Possess Distinct Growth Patterns on Selective and Differential Media (Fig. 3.).
Figure 3 depicts the growth characteristics of isolated colonies from microorganisms obtained from different water sources (Pennypack Creek (a) and Schuylkill River (b)) when cultured on specific types of media. By utilizing various differential and selective media, one can gain insights into the hemolytic activity, lactose fermentation capabilities, and Gram characteristics of microorganisms. This information is crucial for identification and classification purposes, providing valuable insights into the diversity and potential pathogenicity of the microorganisms in the respective water sources. TSA (Tryptic Soy Agar) is a general-purpose medium that supports the growth of a wide range of microorganisms and serves as a positive control for growth and appearance, allowing for a comparison of growth characteristics between the specific media types mentioned above. The Pennypack Creek sample appeared stark white with heavy growth while the Schuylkill River sample appeared off white with heavy growth. Blood Agar (hemolysis): This medium is used to determine the hemolytic activity of microorganisms. By observing the growth characteristics of the isolated colony from Pennypack Creek on Blood Agar (Figure 3a), no hemolytic activity was observed. The Schuylkill River Sample (Figure 3b) demonstrates B-hemolysis of red blood cells. Eosin Methylene Blue (EMB) Agar (Lactose fermentation): EMB agar is a selective and differential medium used to identify organisms that can ferment lactose. Lactose fermentation can indicate the presence of certain types of bacteria, such as coliforms. By assessing the growth characteristics of the isolated colony from Schuylkill River on EMB agar (Figure 3b), the isolated bacteria could ferment lactose while the sample from Pennypack Creek does not ferment lactose (Figure 3a). MacConkey Agar (Gram isolation): MacConkey agar is both a selective and differential medium used to isolate and differentiate Gram-negative bacteria, particularly those that can ferment lactose. It contains specific indicators that help identify lactose fermentation and distinguish between different types of bacteria. The growth characteristics of the isolated colony from the Schuylkill River showed heavy growth via lactose fermentation (Figure 3b) while the isolated colony from Pennypack Creek did not ferment lactose. PEA (Phenylethyl Alcohol) Agar (Gram isolation): PEA agar is a selective medium used to isolate Gram-positive bacteria while inhibiting the growth of Gram-negative bacteria. By observing the growth characteristics of the isolated colony from Schuylkill River on PEA agar the heavy growth indicates it is Gram-positive (Figure 3b). However, the inhibited growth of the Pennypack isolate compared to TSA growth indicates the organism could be gram negative.

Microorganisms Isolated from Various Surface Waters Possess Distinct Nutrient Utilization and Fermentation Profiles (Fig. 4.).
Isolated colonies from SW obtained from Pennypack Creek and Schuylkill River were cultured on specific types of media. (a) Triple Sugar Iron (TSI) is a differential medium commonly used for the identification of enteric bacteria. It contains three sugars (glucose, lactose, and sucrose) and the pH indicator phenol red. The slant portion of the TSI agar allows for the assessment of carbohydrate fermentation, while the butt portion assesses the production of hydrogen sulfide (H2S) gas. The isolated colonies from The Pennypack Creek (a left) showed no fermentation while the isolated colonies from the Schuylkill River (a right) showed glucose fermentation and hydrogen sulfide gas production in TSI agar (Fig. 4a). Simmon’s Citrate agar is a selective and differential medium used to identify bacteria based on their ability to utilize citrate as a sole carbon source (Fig. 4b). It contains bromothymol blue as the pH indicator. Bacteria capable of utilizing citrate will produce alkaline byproducts, causing the medium to change from green to blue. The isolated colony from The Pennypack Creek did not utilize citrate while the isolated colony from the Schuylkill River did utilize citrate (Fig. 4b). Phenol Red Dextrose and Lactose: Phenol Red broth with dextrose and lactose is a differential medium used to assess the ability of microorganisms to ferment carbohydrates (Fig. 4c). The phenol red indicator changes color based on the pH of the medium, reflecting the fermentation patterns of the bacteria. By culturing the isolated colonies from both Pennypack Creek and Schuylkill River in Phenol Red Dextrose and Lactose broth (Fig. 4c), it was determined that the Pennypack Creek isolate did not ferment glucose nor lactose (4c left) while the Schuylkill River isolated fermented both. In summary, the growth characteristics of isolated colonies from the two samples on selective and differential media exhibit variations. On Blood Agar, the Schuylkill River sample demonstrates B-hemolysis of red blood cells, indicating the presence of hemolytic bacteria, while the Pennypack Creek sample does not exhibit any hemolytic activity. On Eosin Methylene Blue (EMB) Agar, the Schuylkill River sample shows the ability to ferment lactose, whereas the Pennypack Creek sample does not ferment lactose. Additionally, the growth characteristics on MacConkey Agar and PEA Agar suggest that the Schuylkill River sample may contain both Gram-positive and Gram-negative bacteria, while the Pennypack Creek sample shows inhibited growth on PEA Agar, indicating a possible Gram-negative bacterium in that sample. The nutrient utilization and fermentation profiles further differentiate the Pennypack Creek and Schuylkill River samples. In Triple Sugar Iron (TSI) medium, the Schuylkill River sample demonstrates glucose fermentation and hydrogen sulfide gas production, while the Pennypack Creek sample shows no fermentation. On Simmon’s Citrate agar, the Schuylkill River sample utilizes citrate as a carbon source, as indicated by the change in color of the medium, whereas the Pennypack Creek sample does not utilize citrate. Similarly, in Phenol Red Dextrose and Lactose broth, the Schuylkill River sample ferments both glucose and lactose, while the Pennypack Creek sample does not exhibit fermentation of either carbohydrate.
Table 1: Characterization of Cultured Bacteria from Surface Water Samples from The Pennypack Creek and Schuylkill River.
| Observation/Test Result | A. Pennypack Isolate | B. Schuylkill Isolate |
| Gram Result | Gram Positive | Gram Negative |
| Cellular Morphology | Cocci | Bacilli |
| Motility | Non-motile | Motile |
| Mannitol Salt Agar | No Growth, non-halophile | No Growth, non-halophile |
| EMB | Weak Growth, No Lactose Fermentation | Heavy Pink Growth. Lactose Fermenter |
| Blood Agar | Gamma-Hemolytic | Beta-Hemolytic |
| MaConkey’s Agar | No Growth, Reinforces gram + and no lactose fermentation | Pink Growth, Reinforces gram – and lactose fermentation |
| Lactose Fermentation | Negative, no lactose fermentation | Positive, lactose fermentation |
| Dextrose Fermentation | Negative, no dextrose fermentation | Positive, lactose fermentation |
| TSI Slant | No fermentation | Glucose fermentation, hydrogen sulfide production |
| Citrate Slant | No Citrate Utilization | Citrate Utilization |
Table 1 Summarizes the data obtained from the culturing of samples taken from the Pennypack Creek (PC) and Schuylkill River (SR). It is evident from the data that the PC Isolate that the organism is a gram positive, non-motile, cocci shaped bacteria (Column A). Furthermore, the PC Isolate is not capable of fermenting either lactose, sucrose, or dextrose (Column A). Finally, the organism is non (Gamma) hemolytic and is unable to utilize citrate as a nutrient (Column A). It is evident from the data that the SR Isolate that the organism is a gram negative, motile, bacilli shaped bacteria (Column B). Furthermore, the SR Isolate is capable of fermenting lactose and dextrose (Column B). Finally, the organism is fully (Beta) hemolytic and can utilize citrate as a nutrient (Column B).

Storm Events Alter Levels of Chemicals Present in Surface Waters from Schuylkill River (Fig. 5.). The data indicates that the influx of water from storms leads to a decrease in the relative concentrations of chemicals overall. Additionally, the levels of free chlorine, copper, and fluoride showed an increase two days after the storm. The pH of the water also decreased post-storm. These findings suggest that storm events have a significant impact on the levels of different chemicals present in the Schuylkill River. This alteration in chemical composition may potentially contribute to changes in biodiversity in the river ecosystem following storm events.

Fig. 6. Genomic DNA Isolation from Surface Waters of Phila. County Waterways
To determine the biodiversity of Philadelphia waterways and to analyze microbial diversity and functional metagenomes, genomic DNA was isolated from various waterways. Firstly, water samples were filtered through 0.2µm filter towers. The filters were sterilely removed, minced, and the genomic DNA was extracted using the PureLink Microbiome DNA Purification kit. Subsequently, the 10μL of extracted DNA was electrophoresed on 0.5% agarose gels along with increasing concentrations of plasmid DNA to serve as a DNA concentration control (Figure 6a) and no genomic DNA was visible. Since no DNA was visible, water was cultured, and bacterial colonies were used to extract genomic DNA from The Wissahickon Creek (Figure 6b). This verified that the genomic DNA extraction kit worked. A repeated attempt was made to extract genomic DNA from water samples (Figure 6c). This demonstrated that for the Darby Creek and Schuylkill River samples, significant DNA was present in the samples (Figure 6c). Subsequent quantification using a NanoDrop 2000 UV Visible Spectrophotometer (Catalogue # ND-2000, Thermo Fisher, Waltham, MA) indicated that genomic DNA was present in all samples in quantities significant enough for metagenomic sequencing (data not shown).

Figure 7. PCR of Full 16s rDNA from genomic DNA isolated from Philadelphia County Waterways.
Figure 7 demonstrates the PCR amplification of the 16s rDNA gene as a preparatory step for DNA sequencing and classification of microorganisms. The 16s rDNA gene serves as a fingerprint for identifying and classifying microbial organisms. In this study, genomic DNA extracted from pre-storm waterways in Philadelphia County was used as the template for PCR amplification. Mastermixes containing primers that span the entirety of the 16s rRNA gene were employed for the PCR reaction. The resulting PCR products were separated by electrophoresis on a 2% Agarose gel and visualized using a V3 Western Workflow System. The full 16s rDNA gene was successfully amplified from the Darby Creek, Wissahickon Creek, and Schuylkill River samples from genomic DNA samples gathered pre-storm event (Figure 7a). The full 16s rDNA gene was successfully amplified from the Darby Creek, Pennypack Creek, Wissahickon Creek, Schuylkill Creek, and Delaware River from genomic DNA samples gathered 2 days post-storm event (Figure 7b). Since we were not able to amplify the 16s rDNA gene for all samples gathered pre and post storm, it was decided that genomic DNA samples would be sent to the sequencing facility (GeneWiz Azenta, South Plainfield, NJ) for 16s rDNA gene amplification prior to sequencing.

Fig. 8. Microbial Diversity of Philadelphia Surface Waters Pre and Post Storm Events.
Figure 8 shows the bacterial community composition of surface water samples from the Darby Creek, Pennypack Creek, Wissahickon Creek, Schuylkill River, and Delaware River Pre and three days post storm events. Bacteria are identified to the Class taxonomic level. SW samples were collected during periods of no precipitation and three days post significant precipitation. Initial analysis of the data at the Level 3 (Class) taxonomy was used to demonstrate the differences observed between samples. Levels of various taxa changed dramatically between pre and post storm samples, with the least diversity in the Delaware River SW sample. This data correlates with previously published data [12]. where the urban samples demonstrated the least microbial diversity. Furthermore, the most prevalent class of microorganisms present was from the class proteobacteria gamma proteobacteria. This class includes potential pathogens such as Escherichia coli, Yersinia, Salmonella, and Salmonella [37].
This study utilized environmental surface water sampling, genomic DNA isolation from surface water samples, cell culturing of isolates from surface water samples, and PCR of 16s rDNA gene prior to metataxonomic analysis. The data suggests that there is great microbial diversity among the tributaries of the Delaware Watershed which is altered by stormwater runoff. This is supported by studies to catalogue the microbial diversity of The Delaware River using PCR and other non-culturing approaches [38]. Furthermore, the data also suggests that storm and pollution events alter the microbial diversity of the Delaware River Watershed. We used QIIME2, a powerful bioinformatics tool, to perform a metataxonomic analysis of our data. Its tools were used for processing, analyzing and visualizing taxonomic data to identify the composition of the microbial communities [39]. It is interesting to note that the most prevalent class of microorganisms present was from the class proteobacteria gamma proteobacteria. This class includes potential pathogens such as Escherichia coli, Yersinia, Salmonella, and Salmonella [38]. All these bacterial genera are potential human pathogens.
To our knowledge, much has been done to measure the pollution events and presence of fecal coliforms in these waterways, but no data exists on the impact to microbial diversity at a community level using a metataxonomic/metagenomic approach. And the problem is getting worse. Between July 2017 and June 2018, the combined overflow of the CSOs in Philadelphia County occurred around 6,500 instances, releasing approximately 12.5 billion gallons of untreated wastewater and raw sewage [20]. And with rainfall increasing to an average of 8 inches more per year vs. the 20th century, the problem is likely to get worse [40]. The results suggest that anthropogenic contaminants and storm events can significantly impact microbial diversity in aquatic ecosystems. When sewage discharge enters surface water bodies, it carries an assortment of disease-causing microorganisms that have the potential to cause waterborne illnesses if this contaminated water is utilized for household and other activities [41]. Worldwide, approximately 58% of wastewater generated in urban regions and 81% of industrial waste are directly released into water sources without proper or sufficient treatment, leading to the pollution of approximately 73% of these water bodies [42]. The findings emphasize the need for further investigation into the effects of pollution on microbial communities and highlight the importance of understanding the potential consequences for ecosystem functioning and human health. Therefore, “maintaining the quality of aquatic ecosystems represents one of the most formidable challenges facing global society in the twenty-first century” [43]. Our work to further understand the impact of storm waters/pollution on microbial diversity using a taxonomic approach will further elucidate the scope of the problem and the best means of mitigating it. Our metagenomic study of these same waters will allow us to determine the impact on the functional capacity of these ecosystems.
Conclusion
To better understand the impact of stormwater and pollution events on the microbial diversity of the Delaware River, a more sophisticated approach to identifying and quantifying pollutants such as using mass spectroscopy or HPLC will improve our ability to correlate pollution events with changes in microbial diversity [44]. Furthermore, using more sophisticated tools in the field to measure turbidity, dissolved oxygen, pH and other parameters may also provide a clearer picture of the impact of these storms or pollution events on the microbial community [45].
To better understand the impact of anthropogenic pollution on microbial diversity in Philadelphia waterways, we are constructing recirculating microcosms of the various waterways. The microcosms will incorporate aspects from the designs of two well studied systems [46, 47]. Briefly, an aquarium pump and vinyl tubing will recirculate the water through an acrylic channel lined with unglazed ceramic tiles as a substrate for biofilm growth. Two systems will be inoculated with water from each location of interest, one experimental and one control. They will be inoculated with surface water from the locations being studied. Microcosms are very useful in examining how microbial communities change over time and in response to pollutants at both a species diversity level and functional capacity. For example, through altering the number of species within a pool and adjusting nutrient availability (which impacts species interactions), researchers determined that communities with greater complexity exhibited lower long-term stability [48]. Recently, Other studies have shown that microcosms can mirror the functional capacity of biofilms in aquatic ecosystems. Furthermore, Microcosm studies provide evidence that interactions with biofilms in freshwater ecosystems lead to swift degradation and elimination of widely used herbicides [49]. Other studies have shown bioprecipitation of realgar (As4S4) within a microcosm supplied with natural groundwater and organic material [50]. The ability to manipulate environmental factors and examine their effects on microbial growth patterns within the microcosm will provide insight into the effects of pollutants on microbial diversity and correlate to observed changes in microbial populations observed within the natural environments being studied. The recent Trinseo Altuglas chemical spill in Bristol Pennsylvania will give inspiration for possible experimental contaminants [51]. During this event, 12,000 gallons of latex polymers and trace various acrylates was spilled into the Delaware River. We plan to recreate these conditions using microcosms and compare the biofilm and surface water samples taken at the site the day after the spill in the field with our recreations using the microcosms.
Furthermore, our preliminary data will require further taxonomical, statistical, and metagenomic analysis of the microbial communities present in our water samples, by using taxonomic classification to identify the specific microbial taxa from sequenced data. In addition, a metagenomic approach using full genome sequences will allow us to determine the changes in functional capacity of these microbial communities, identifying enrichment for species with genes capable of metabolizing various pollutants [40]. Further analysis will involve next-generation sequencing, and bioinformatic analysis using tools such as QIIME 2 and Keemei. Of note, there was very little genomic DNA obtained from the Delaware River SW samples post-storm. A switch from SW samples to biofilms should yield much greater concentrations of genomic DNA, allowing for a more robust analysis of taxa and metagenomic analysis. We are also developing a tool written in the python programming language that incorporates the QIIME2 and Sklearn libraries to perform taxonomic classifications. QIIME2 will be used in pre-processing the data by performing tasks such as denoising, filtering, and feature table generation. Sklearn will be used to apply classification models for taxonomic assignment. The goal for this tool will be to help streamline the classification process and to efficiently analyze the data from our water samples. The combinations of surface water, biofilm, and microcosm microbial diversity studies will greatly enhance our understanding of the impact of anthropogenic pollution on microbial communities in our waterways.
Over the past fifty years, significant improvements have been observed in the condition of the Delaware River following the implementation of the Delaware River Basin Commission (DRBC) Compact in 1961 and the enactment of amendments to the Federal Clean Water Act during the 1970s [52]. Yet much work remains to be done to make the river healthier for many threatened species. Researchers from the Delaware Estuary Program and the DRBC are trying to establish stricter dissolved oxygen standards within the tidal Delaware River, aiming for a minimum of 5.0 mg/L to safeguard the continuous reproduction of anadromous fish species like the American shad and Atlantic sturgeon [53]. These efforts will be exacerbated by climate change, with alterations in temperature and precipitation having a potential impact on the occurrence of a water crisis in Philadelphia, should the present management practices of the Delaware River basin be maintained [54]. Much work is being done to understand how the Delaware River and its tributaries influence phytoplankton blooms in the Delaware Bay Estuaries. The abundance of phytoplankton in estuaries is governed by intricate biological and chemical mechanisms that regulate both growth and mortality, as well as by physical processes that oversee the movement and dilution of these organisms [55]. With the continued development of Philadelphia County and climate change likely to have an even greater impact on the Delaware River basin, it is more important than ever to understand the impact of water management and storm/pollution events on the microbial diversity of these waterways. To achieve a better understanding of these dynamics we must employ systems based, metataxonomic and metagenomic approach.
The utilization of whole genome sequencing metagenomics technique allows for the comprehensive study of the complete genetic content of all microbiota members in a natural habitat [56]. This approach offers several benefits in understanding microbial communities. Firstly, it enables the study of highly diverged microbes, including viruses, which may have been challenging to analyze using traditional methods [57]. Secondly, it provides close estimations of microbial diversity by capturing a wide range of microbial species present in the environment. Additionally, it allows for the detection of the abundance of microorganisms across various habitats, shedding light on their distribution patterns [58]. The analysis of unculturable microorganisms, which are difficult to grow in laboratory settings, becomes possible through this technique [59]. Furthermore, whole genome sequencing provides insights into the composition and functional capabilities of an ecosystem, offering a comprehensive understanding of the microbial community. Lastly, it allows for the investigation of functional genes and gene clusters, aiding in the exploration of specific traits and potential metabolic pathways within the microbiota [60]. Overall, the application of metagenomics will greatly enhance our knowledge of microbial ecosystems of the Delaware Watershed and their functional response to storm/pollution events.
Acknowledgements
This work was supported by the National Science Foundation (NSF) under NSF ATE subaward #231296 NSF-Micro Nano Technology Collaborative.
Disclosures
The authors declare no conflicts of interest.
[1] S. D. Allison and J. B. Martiny, “Colloquium paper: resistance, resilience, and redundancy in microbial communities,” Proceedings of the National Academy of Sciences of the United States of America 105 Suppl 1(Suppl 1), 11512–11519 (2008). [https://doi.org/10.1073/pnas.0801925105]
[2] N. Fanin, M. J. Gundale, M. Farrell, M. Ciobanu, J. A. Baldock, M. C. Nilsson, P. Kardol, and D. A. Wardle, “Consistent effects of biodiversity loss on multifunctionality across contrasting ecosystems,” Nature Ecology & Evolution 2(2), 269–278 (2018). [https://doi.org/10.1038/s41559-017-0415-0]
[3] N. R. Pace, “A molecular view of microbial diversity and the biosphere,” Science (New York, N.Y.) 276(5313), 734–740 (1997). [https://doi.org/10.1126/science.276.5313.734]
[4] W. B. Whitman, D. C. Coleman, and W. J. Wiebe, “Prokaryotes: the unseen majority,” Proceedings of the National Academy of Sciences of the United States of America 95(12), 6578–6583 (1998). [https://doi.org/10.1073/pnas.95.12.6578]
[5] K. Besemer, “Biodiversity, community structure and function of biofilms in stream ecosystems,” Research in Microbiology 166(10), 774-781 (2015). [https://doi.org/10.1016/j.resmic.2015.05.006]
[6] T. J. Battin, L. A. Kaplan, J. Denis Newbold, and C. M. Hansen, “Contributions of microbial biofilms to ecosystem processes in stream mesocosms,” Nature 426(6965), 439–442 (2003). [https://doi.org/10.1038/nature02152]
[7] M. E. Davey and G. A. O’toole, “Microbial biofilms: from ecology to molecular genetics,” Microbiology and Molecular Biology Reviews : MMBR 64(4), 847–867 (2000). [https://doi.org/10.1128/MMBR.64.4.847-867.2000]
[8] T. B. Atherholt, M. W. LeChevallier, W. D. Norton, and J. S. Rosen, “Effect of rainfall on Giardia and Crypto,” Journal‐American Water Works Association 90(9), 66-80 (1998). [https://doi.org/10.1002/j.1551-8833.1998.tb08499.x]
[9] R. Schwartz, J. Levin, and R. Goldstein, “Drinking water turbidity and gastrointestinal illness in the elderly of Philadelphia,” Journal of Epidemiology & Community Health 54(1), 45-51 (2000). [https://doi.org/10.1136/jech.54.1.45]
[10] W. E. Oswald and J. R. Lippy, “Comparison of fluorescence and microscope methods for detection of giardia cysts and cryptosporidium oocysts in water samples,” Applied and Environmental Microbiology 59(6), 1728-1731 (1993). [https://doi.org/10.1128/aem.59.6.1728-1731.1993]
[11] L. Villegas, L. A. Schneider, A. B. Carbrey, and V. H. Burkholder, “Adhesion of giardia cysts and cryptosporidium oocysts to soil particles,” Journal of Environmental Quality 28(5), 1472–1481 (1999). [https://doi.org/10.2134/jeq1999.00472425002800050002x]
[12] J. Muurinen et al., “Antibiotic resistomes and microbiomes in the surface water along the Code River in Indonesia reflect drainage basin anthropogenic activities,” Environmental Science & Technology 56(21), 14994-15006 (2022). [https://doi.org/10.1021/acs.est.2c01570]
[13] J. H. K. Eng, A. R. Massoudieh, C. J. C. Dore, R. M. Tuthill, and G. A. Fox, “Removal and inactivation of Giardia lamblia and Cryptosporidium parvum from surface water,” Journal of Environmental Engineering 132(5), 541–552 (2006). [https://doi.org/10.1061/(asce)0733-9372(2006)132:5(541)]
[14] X. Cheng, J. Forsythe, and E. Peterkin, “Biogeochemical Approaches to Assess PAH Pollution in an Urban Waterway,” Water Environment Research: A Research Publication of the Water Environment Federation 87(12), 2107–2119 (2015). [https://doi.org/10.2175/106143015X14362865227436]
[15] J. L. Salerno, B. Little, J. Lee, and L. J. Hamdan, “Exposure to crude oil and chemical dispersant may impact marine microbial biofilm composition and steel corrosion,” Frontiers in Marine Science 5, 196 (2018). [https://doi.org/10.3389/fmars.2018.00196]
[16] M. Ma, Y. Li, S. R. Adham, J. H. Lee, and C. W. Han, “Occurrence, removal and seasonal variation of Cryptosporidium and Giardia in the Yongdam water purification plant, Korea,” Water Science and Technology: A Journal of the International Association on Water Pollution Research 47(3), 139-144 (2003). [https://doi.org/10.2166/wst.2003.0125]
[17] J. Muurinen et al., “Antibiotic resistomes and microbiomes in the surface water along the Code River in Indonesia reflect drainage basin anthropogenic activities,” Environmental Science & Technology 56(21), 14994-15006 (2022). [https://doi.org/10.1021/acs.est.2c01570]
[18] R. Schwartz, J. Levin, and K. Hodge, “Drinking water turbidity and pediatric hospital use for gastrointestinal illness in Philadelphia,” Epidemiology (Cambridge, Mass.) 8(6), 615–620 (1997). [https://doi.org/10.1097/00001648-199710000-00001]
[19] R. Schwartz, J. Levin, and R. Goldstein, “Drinking water turbidity and gastrointestinal illness in the elderly of Philadelphia,” Journal of Epidemiology & Community Health 54(1), 45-51 (2000). [https://doi.org/10.1136/jech.54.1.45]
[20] F. Kummer, “Climate change is straining Philly’s 19th-century sewage system. Ida was a “wake-up call,”” The Philadelphia Inquirer (September 10, 2021). [https://www.inquirer.com/science/climate/philadelphia-ida-floding-manayunk-climate-change-sewer-system-20210910.html]
[21] G. B. Thomas and D. Crawford, “London Tideway Tunnels: tackling London’s Victorian legacy of combined sewer overflows,” Water Science and Technology: A Journal of the International Association on Water Pollution Research 63(1), 80–87 (2011). [https://doi.org/10.2166/wst.2011.012]
[22] S. L. McLellan, J. C. Fisher, and R. J. Newton, “The microbiome of urban waters,” International Microbiology: The Official Journal of the Spanish Society for Microbiology 18(3), 141–149 (2015). [https://doi.org/10.2436/20.1501.01.244]
[23] A. Montserrat et al., “Using data from monitoring combined sewer overflows to assess, improve, and maintain combined sewer systems,” The Science of the Total Environment 505, 1053–1061 (2015). [https://doi.org/10.1016/j.scitotenv.2014.10.087]
[24] G. Xiao and J. B. Mankin, “Ultraviolet disinfection of giardia lamblia cysts in water,” Journal of Environmental Science and Health. Part A, Environmental Science and Engineering & Toxic and Hazardous Substance Control 27(8), 2169–2183 (1992). [https://doi.org/10.1080/10934529209376189]
[25] “CSOcast beta,” CSOcast (n.d.). [https://water.phila.gov/maps/csocast/#:~:text=About%2060%20percent%20of%20Philadelphia,polluted%20water%20to%20treatment%20plantsystem-20210910.html]
[26] W. J. De Roever, L. A. Mostert, and R. F. Barnard, “Giardia cysts: isolation, freeze-thaw resistance, and viability as indicators of the efficiency of treatment of drinking water,” Applied and Environmental Microbiology 32(1), 76-79 (1976). [https://doi.org/10.1128/aem.32.1.76-79.1976]
[27] M. R. Mazzola, M. J. Arnone, and R. W. Berg, “Giardiasis in hikers from the Olympic National Park, Washington,” The American Journal of Tropical Medicine and Hygiene 47(5), 543–548 (1992). [https://doi.org/10.4269/ajtmh.1992.47.543]
[28] Combined sewer overflows frequently asked questions (no date) CT.gov. Available at: https://portal.ct.gov/DEEP/Municipal-Wastewater/Combined-Sewer-Overflows-Frequently-Asked-Questions (Accessed: 12 September 2023).
[29] A. Free, M. A. McDonald, and E. Pagaling, “Diversity-function relationships in natural, applied, and engineered microbial ecosystems,” in Advances in Applied Microbiology (Vol. 105, Academic Press, 2018), pp. 131-189. [https://doi.org/10.1016/bs.aambs.2018.07.002]
[30] L. R. Thompson, J. G. Sanders, D. McDonald, A. Amir, J. Ladau, K. J. Locey, … R. Knight, “A communal catalogue reveals Earth’s multiscale microbial diversity,” Nat. 551(7681), 457–463 (2017). [https://doi.org/10.1038/nature24621]
[31] T. J. Wade, E. Sams, K. P. Brenner, R. Haugland, E. Chern, M. Beach, L. Wymer, C. C. Rankin, D. Love, Q. Li, R. Noble, and A. P. Dufour, “Rapidly measured indicators of recreational water quality and swimming-associated illness at marine beaches: a prospective cohort study,” Environmental Health: A Global Access Science Source 9, 66 (2010). [https://doi.org/10.1186/1476-069X-9-66]
[32] R. Hinlo, D. Gleeson, M. Lintermans, and E. Furlan, “Methods to maximize recovery of environmental DNA from water samples,” PLoS ONE 12(6), e0179251 (2017). [https://doi.org/10.1371/journal.pone.0179251]
[33] Nick Weber, David Liou, Jennifer Dommer, Philip MacMenamin, Mariam Quiñones, Ian Misner, Andrew J Oler, Joe Wan, Lewis Kim, Meghan Coakley McCarthy, Samuel Ezeji, Karlynn Noble, Darrell E Hurt, “Nephele: a cloud platform for simplified, standardized and reproducible microbiome data analysis,” Bioinformatics 34(8), 1411–1413 (2018). [https://doi.org/10.1093/bioinformatics/btx617]
[34] R. C. Edgar and H. Flyvbjerg, “Error filtering, pair assembly and error correction for next-generation sequencing reads,” Bioinformatics 31(21), 3476–3482 (2015). [https://doi.org/10.1093/bioinformatics/btv401]
[35] T. Z. DeSantis et al., “Greengenes, a chimera-checked 16S rRNA gene database and workbench compatible with ARB,” Applied and Environmental Microbiology 72(7), 5069–5072 (2006). [https://doi.org/10.1128/AEM.03006-05]
[36] Y. Thairu, I. N. Abdullahi, and Y. Usman, “Laboratory perspective of gram staining and its significance in investigations of infectious diseases,” Sub-Saharan African Journal of Medicine 1(4), 168 (2014). [https://doi.org/10.4103/2384-5147.144725]
[37] J. J. Berman, “Taxonomic Guide to Infectious Diseases: Understanding the Biologic Classes of Pathogenic Organisms,” Academic Press (2019).
[38] M. T. Cottrell, L. A. Waidner, L. Yu, and D. L. Kirchman, “Bacterial diversity of metagenomic and PCR libraries from the Delaware River,” Environmental Microbiology 7(12), 1883-1895 (2005). [DOI: 10.1111/j.1462-2920.2005.00762.x]
[39] 13. Mugge, R. L., Salerno, J. L., & Hamdan, L. J. (2021). Microbial Functional Responses in Marine Biofilms Exposed to Deepwater Horizon Spill Contaminants. Frontiers in Microbiology, 12, 636054. https://doi.org/10.3389/fmicb.2021.636054
[40] F. Kummer, “The secret scourge of climate change? More raw sewage in Philadelphia’s waterways,” The Philadelphia Inquirer, September 13, 2019. [https://www.inquirer.com/science/climate/delaware-schuylkill-river-combined-sewer-stormwater-sewage-climate-change-20190913.html]
[41] World Health Organization. (2006). WHO guidelines for the safe use of wasterwater excreta and greywater (Vol. 1). World Health Organization.
[42] Vargas-González, H. H., Arreola-Lizárraga, J. A., Mendoza-Salgado, R. A., Méndez-Rodríguez, L. C., Lechuga-Deveze, C. H., Padilla-Arredondo, G., & Cordoba-Matson, M. (2014). Effects of sewage discharge on trophic state and water quality in a coastal ecosystem of the Gulf of California. The Scientific World Journal, 2014. doi: 10.1155/2014/618054
[43] Hampel, M., Blasco, J., & Segner, H. (2015). Molecular and cellular effects of contamination in aquatic ecosystems. Environmental science and pollution research, 22, 17261-17266. DOI: 10.1007/s11356-015-5565-5
[44] Bletsou, A. A., Jeon, J., Hollender, J., Archontaki, E., & Thomaidis, N. S. (2015). Targeted and non-targeted liquid chromatography-mass spectrometric workflows for identification of transformation products of emerging pollutants in the aquatic environment. TrAC Trends in Analytical Chemistry, 66, 32-44. https://doi.org/10.1016/j.trac.2014.11.009
[45] Lazorchak, J. M., Klemm, D. J., & Peck, D. V. (Eds.). (1998). Environmental monitoring and assessment program surface waters: field operations and methods for measuring the ecological condition of wadeable streams.
[46] Ashelford, K. E., Fry, J. C., Day, M., Hill, K. E., Learner, M., Marchesi, J. R., Perkins, C., & Weightman, A. J. (1997). Using microcosms to study gene transfer in aquatic habitats. FEMS Microbiology Ecology, 23(2), 81–94. https://doi.org/10.1111/j.1574-6941.1997.tb00393.
[47] Singer, G., Besemer, K., Hödl, I., Chlup, A., Hochedlinger, G., Stadler, P. F., & Battin, T. J. (2006). Microcosm design and evaluation to study stream microbial biofilms. Limnology and Oceanography-methods, 4(11), 436–447. https://doi.org/10.4319/lom.2006.4.43
[48] Hu, J., Amor, D. R., Barbier, M., Bunin, G., & Gore, J. (2022). Emergent phases of ecological diversity and dynamics mapped in microcosms. Science (American Association for the Advancement of Science), 378(6615), 85-89. https://doi.org/10.1126/science.abm7841
[49] Bighiu, M. A., & Goedkoop, W. (2021). Interactions with freshwater biofilms cause rapid removal of common herbicides through degradation – evidence from microcosm studies. Environmental Science–Processes & Impacts, 23(1), 66. https://doi.org/10.1039/d0em00394h
[50] Falteisek, L., Duchoslav, V., & Drahota, P. (2019). Realgar (As4S4) bioprecipitation in microcosm fed by natural groundwater and organic matter. Environmental Science and Pollution Research International, 26(18), 18766-18776. https://doi.org/10.1007/s11356-019-05237-4
[51] Briggs, R. W. (2023, March 27). Bristol plant that spilled chemicals into Philly’s water supply had other mishaps over the last decade. https://www.inquirer.com. https://www.inquirer.com/news/trinseo-chemical-spill-delaware-river-bristol-township-20230327.html
[52] Mandarano, L. A., Featherstone, J. P., & Paulsen, K. (2008). Institutions for interstate water resources management 1. JAWRA Journal of the American Water Resources Association, 44(1), 136-147. https://doi.org/10.1111/j.1752-1688.2007.00143.x
[53] Kauffman, G. J. (2018). The cost of clean water in the Delaware River Basin (USA). Water, 10(2), 95. https://doi.org/10.3390/w10020095
[54] Wolock, D. M., McCabe Jr, G. J., Tasker, G. D., & Moss, M. E. (1996). Effects of climate change on water resources in the Delaware River basin. Water resources management in the face of climatic/hydrologic uncertainties., 202-224. DOI:10.1111/j.1752-1688.1993.tb03225.x
[55] Dijkstra, Y. M., Chant, R. J., & Reinfelder, J. R. (2019). Factors controlling seasonal phytoplankton dynamics in the Delaware River Estuary: an idealized model study. Estuaries and coasts, 42, 1839-1857. https://doi.org/10.1007/s12237-019-00612-3
[56] Pérez-Cobas, A. E., Gomez-Valero, L., & Buchrieser, C. (2020). Metagenomic approaches in microbial ecology: an update on whole-genome and marker gene sequencing analyses. Microbial genomics, 6(8), mgen000409. https://doi.org/10.1099/mgen.0.000409
[57] Edwards, R. A., & Rohwer, F. (2005). Viral metagenomics. Nature Reviews Microbiology, 3(6), 504-510. DOI: https://doi.org/10.1038/nrmicro1163
[58] Ferguson, C., Husman, A. M. D. R., Altavilla, N., Deere, D., & Ashbolt, N. (2003). Fate and transport of surface water pathogens in watersheds. https://doi.org/10.1080/10643380390814497
[59] Drancourt, M., Berger, P., & Raoult, D. (2004). Systematic 16S rRNA gene sequencing of atypical clinical isolates identified 27 new bacterial species associated with humans. Journal of clinical microbiology, 42(5), 2197-2202. doi: 10.1128/JCM.42.5.2197-2202.2004
[60] Yen, S., & Johnson, J. S. (2021). Metagenomics: a path to understanding the gut microbiome. Mammalian genome : official journal of the International Mammalian Genome Society, 32(4), 282–296. https://doi.org/10.1007/s00335-021-09889-x